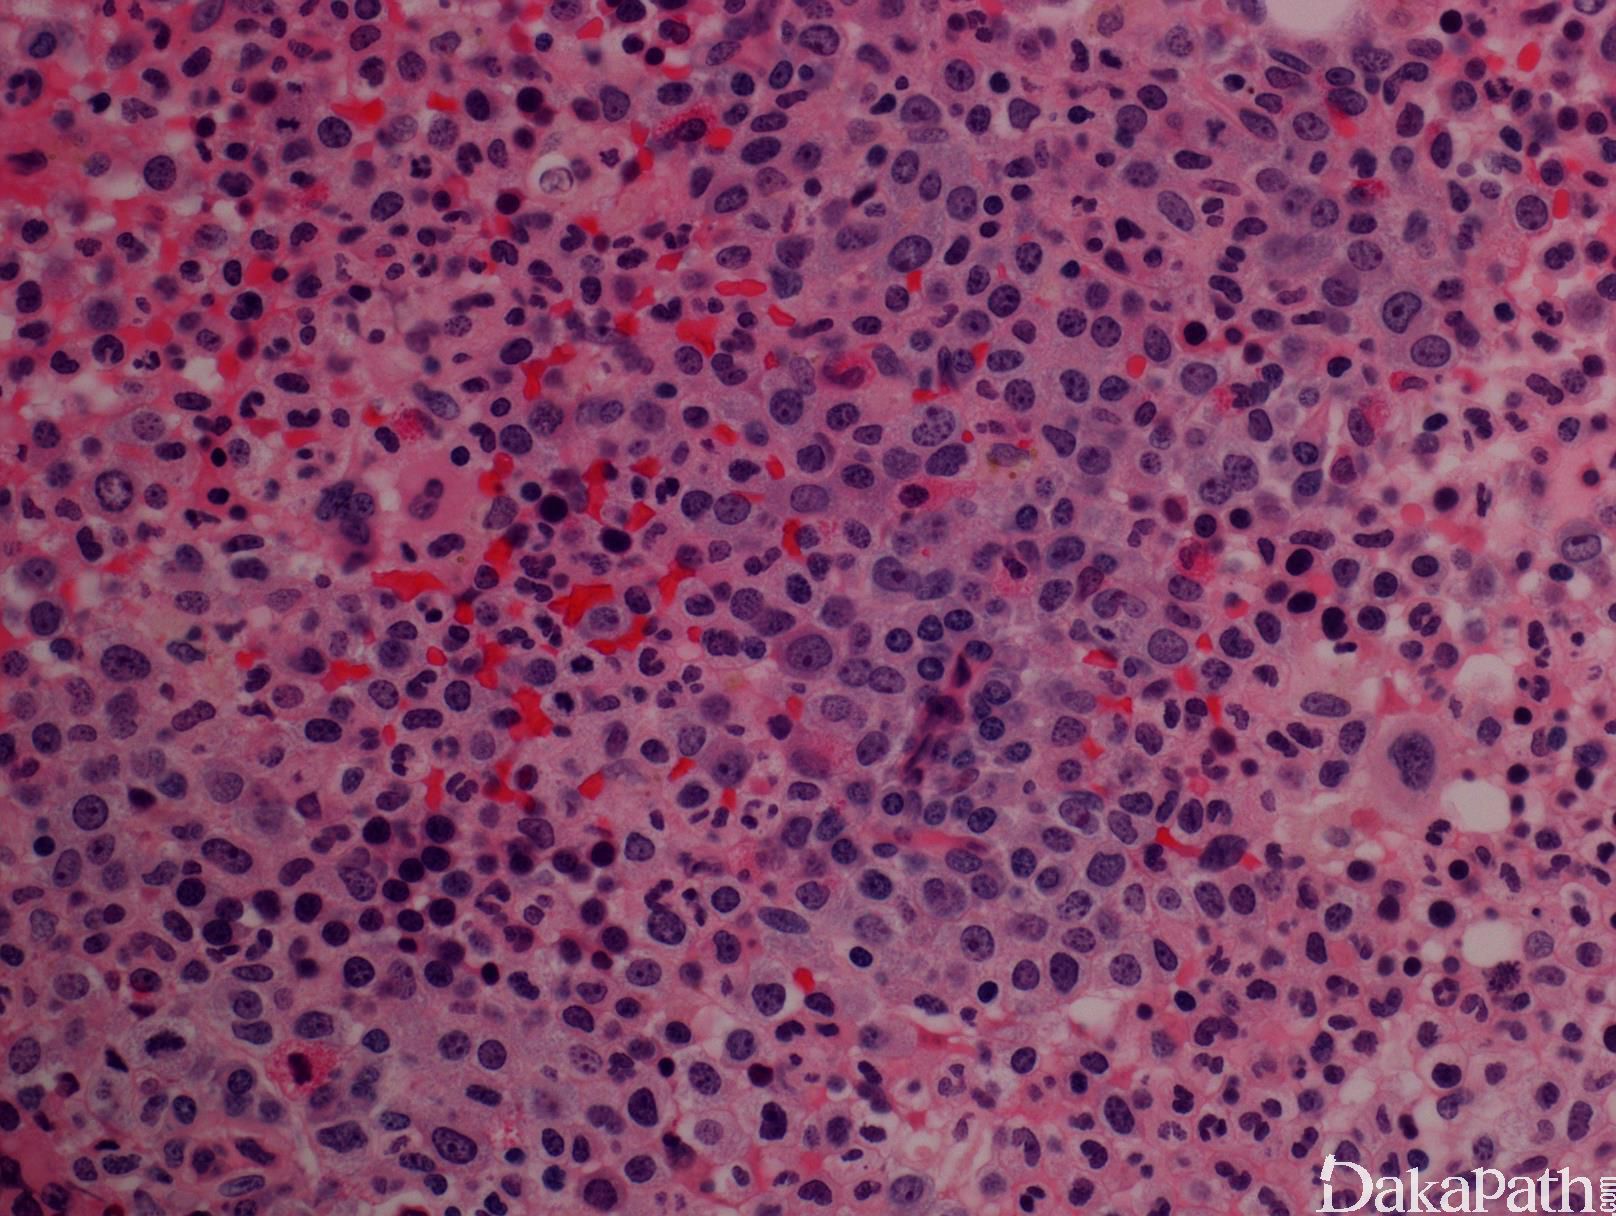

骨髓增生异常/骨髓增生肿瘤,不能分类
Myelodysplastic/Myeloproliferative Neoplasm, Unclassifiable (MDS/MPN, U)
概述:
骨髓异型增生/骨髓增生性肿瘤-不能分类,其初诊时在临床、实验室和形态学方面具有骨髓异型增生和骨髓增生性肿瘤的双重特征,故符合骨髓异性增生/骨髓增生性肿瘤的诊断,但又不符合任一亚类(CMML、aCML、JMML 和 RARS-T)的诊断标准。
诊断要点:
临床表现、血液及形态学
临床表现与 MDS 和 MPN 重叠。形态学上既有一系或多系无效造血/异型增生又同时有另一系或多系的有效增生。可有不同程度贫血、血小板增多(≥450×109/L)、白细胞增高(≥13×109/ L)。粒细胞可以有异型,可见巨血小板。骨髓有核细胞增生,可以是单一髓系或所有髓系增生,同时至少有一系有明显异型性。
需要特别注意的是,只有经过必要的临床、形态学、免疫表型和遗传学检查确定疾病符合 MDS/MPN,但又不能归类为某一具体类型时,使用 MDS/MPN-U 这一术语才是合理的。对于以前已诊断为 MPN,在疾病的进展中出现异型增生(MDS)特征的病例,不能诊断为 MDS/MPN-U。但是,MDS/MPN-U 却可能包括了部分这些病例:初诊时即有 MDS 特征,系由 MPN 进展而来,但无早期 MPN 的证据。接受生长因子治疗的患者不宜诊断 MDS/MPN-U,需观察随访除外治疗导致的改变。
诊断标准(2017 年版 WHO ):
髓系肿瘤,发病时具有髓系增生和发育异常的混合特征,不符合 WHO 对任何其它 MDS/MPN、MDS 或 MPN 的诊断标准
- 外周血和骨髓中原始细胞<20%
- 临床和形态上具有骨髓增生异常综合症中任一亚型的特征 a;
临床和形态上具有骨髓增生性特征,表现为血小板 ≥450×109/L 伴巨核增生,和/或白细胞 ≥13×109/ L;
无细胞毒化疗或生长因子治疗史(其有可能导致 MDS/MPN 样改变);
无 PDGFRA、PDGFRB 或 FGFR1 重排,无 PCM1-JAK2 重组。
a 符合 MDS 伴孤立 del(5q)诊断标准的病例除外,即使有血小板或白细胞增高。
鉴别诊断:
MDS 或 MPN: 分两种情况, 一种是有 MDS 或 MPN 病史,就诊时由于疾病进展,形态类似 MDS/MPN 或 MDS/MPN-U;第二种情况是初诊原发的 MDS 或 MPN。这两种情况都需要与 MDS/MPN-U 加以鉴别。 MDS/MPN-U 可能包括了前一种情况的部分病例(没有确切原发病史或特征)。
MDS/MPN 亚型: 各亚型都有自己的特征,如 CMML 主要表现为外周血单核细胞增多;aCML 表现为粒细胞增生伴异型;JMML 发生于儿童,外周血粒和单核细胞增生,可伴有血红蛋白 F 增高,7 号单染色体。详细参见 WHO 诊断标准。
生长因子治疗反应性改变: 形态学有时可类似 MDS/MPN-U,用药史可以鉴别,必要时停药一段时间后复查。
预后:
这方面资料有限。最近一项研究表明总体中位生存期为 21.8 个月,无白血病生存期为 18.9 个月。